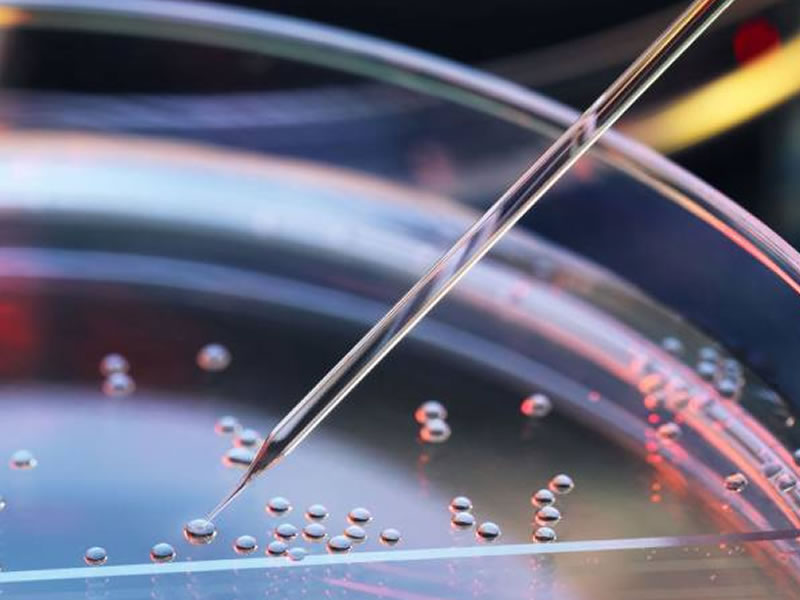
/17941ciencia3001.jpg

Editoria Ciência

Aranha descoberta na Colômbia recebe nome de vilões de Star Wars
As aranhas de patas calvas, consideradas as mais enigmáticas da ordem das m...

Funcionária do Google quebra recorde mundial do PI
Projeto - que durou 4 meses e utilizou 25 servidores em nuvem - conseguiu p...

Califórnia adota tecnologia para proteger abelhas de pesticidas
Todo o esforço é para ajudar as abelhas, protegê-las e colocá-las no mapa ...

Meta de reduzir efeitos de produtos químicos não será alcançada, diz ONU
O alerta foi feito durante a 4ª Assembleia das Nações Unidas para o Meio Am...

Brasileiros estudam novo material para microdispositivos eletrônicos
O material pesquisado por cientistas brasileiros pode superar o grafeno com...

Vírus identificados na China infectam carrapatos bovinos no Brasil
Carrapato bovino causa perdas severas para a pecuária brasileira, chegando ...

Universidade israelense revela nova coleção de manuscritos de Einstein
"A nova coleção joga luz sobre o cientista e o homem após a ciência", afirm...

ESA revela evidências de que Marte tinha sistema de águas subterrâneas
O nível de água "coincide com um suposto oceano marciano que acredita-se qu...

Você sabe por que a potência dos motores é medida em cavalos?
Provavelmente, você já ouviu falar sobre o termo “cavalos de potência” (ou ...

Cientistas questionam papel de asteroide na extinção dos dinossauros
Pesquisadores consideram que erupções vulcânicas podem ter contribuído para...

Provas de aquecimento global causado pelo homem atingem “padrão ouro”
"Padrão" foi aplicado em 2012 para confirmar a descoberta da partícula suba...

Astrônomos encontram a menor lua do planeta Netuno
Chamada Hipocampo, ela faz parte do conjunto de sete luas interiores de Net...

A ciência por trás do experimento agrícola mais longo da história
Em curso há 176 anos, experimento de Broadbalk já trouxe diversas respostas...

Dupla feminina fará caminhada espacial pela 1ª vez, diz astronauta
A astronauta Christina Koch se juntará à Anne McClain em plataforma orbital...

Terra está mais verde hoje do que há 20 anos graças a estes dois países
Surpreendentemente, Índia e China, nações mais populosas do globo, lideram ...

Insetos enfrentam extinção em massa — e vão trazer tudo abaixo consigo
Pequeninos e muitas vezes ignorados, os insetos são as pedras fundamentais ...

Descoberta sobre células-tronco pode levar à cura do diabetes
Pesquisadores da Universidade da Califórnia em São Francisco deram "passo c...

Estudo aponta que abelhas são capazes de resolver operações matemáticas
Pesquisa buscou entender relação entre tamanho do cérebro e sua potência, o...

Dinossauro que se defendia com espinhos é descoberto na Argentina
Chamado Bajadasaurus pronuspinax, o dinossauro pertence à família dos dicra...
Células-tronco ajudam a recuperar área cerebral danificada por AVC
A técnica pode ajudar na recuperação de vítimas de acidente vascular cerebr...
Nós usamos cookies e outras tecnologias semelhantes para melhorar a sua experiência em nossos serviços, personalizar publicidade e recomendar conteúdo de seu interesse. Ao utilizar nossos serviços, você concorda com tal monitoramento. Informamos ainda que atualizamos nossa


